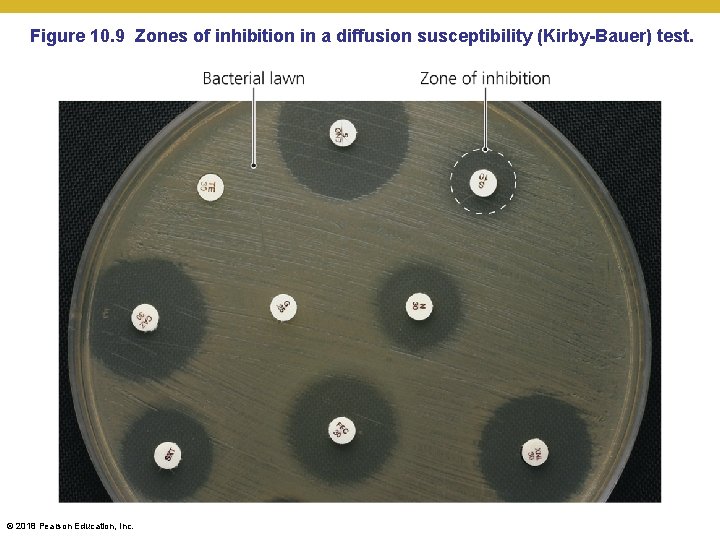
Figure 10. 9 Zones of inhibition in a diffusion susceptibility (Kirby-Bauer) test. © 2018
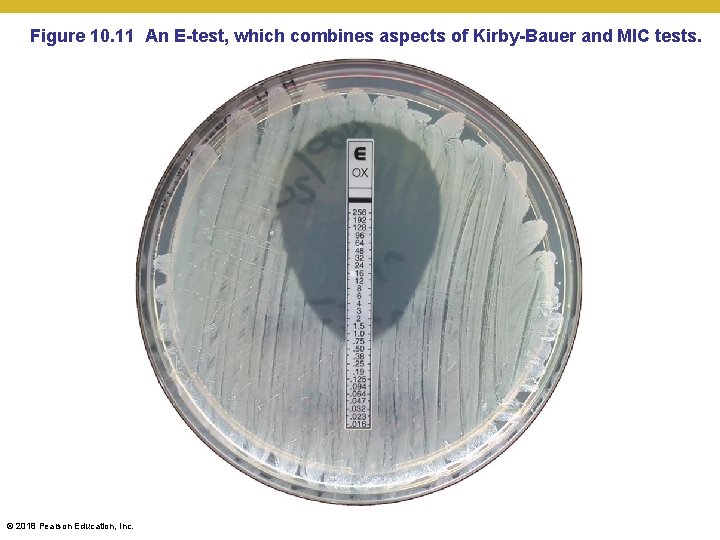
Figure 10. 11 An E-test, which combines aspects of Kirby-Bauer and MIC tests. ©

Microbiology Chapter 10 Antimicrobial Drugs 2018 Pearson Education

Microbiology Chapter 10 Antimicrobial Drugs © 2018 Pearson Education, Inc.

The History of Antimicrobial Agents • Drugs • Chemicals that affect physiology in any manner • Chemotherapeutic agents • Drugs that act against diseases • Antimicrobial agents (antimicrobials) • Drugs that treat infections © 2018 Pearson Education, Inc.

The History of Antimicrobial Agents • Paul Ehrlich • “Magic bullets” • Arsenic compounds that killed microbes (e. g. Treponema pallidum – syphillis) • Alexander Fleming • Penicillin released from Penicillium killed bacteria • Gerhard Domagk • Discovered sulfanilamide – broad spectrum activities • Selman Waksman • Antibiotics (coined the word) • Antimicrobial agents produced naturally by soil organisms © 2018 Pearson Education, Inc.

Figure 10. 1 Antibiotic effect of the mold Penicillium chrysogenum. © 2018 Pearson Education, Inc.

The History of Antimicrobial Agents • Semisynthetics • Chemically altered naturally-produced antibiotics that are more effective, longer lasting, or easier to administer than naturally occurring ones • Synthetics • Antimicrobials that are completely synthesized in a lab • Often cheaper, especially when produced in bulk • Greatly allows the development of fare more diverse derivatives © 2018 Pearson Education, Inc.

Table 10. 1 Sources of Some Common Antibiotics and Semisynthetics © 2018 Pearson Education, Inc.

Mechanisms of Antimicrobial Action • Successful chemotherapy requires selective toxicity • Antibacterial drugs constitute largest number and diversity of antimicrobial agents (big difference between humans and bacteria, but less difference between humans and mitochondria…why? ) • Fewer drugs to treat eukaryotic infections • Antiviral drugs limited (DNA polymerases too similar in structure) © 2018 Pearson Education, Inc.

Figure 10. 2 Mechanisms of action of microbial drugs. © 2018 Pearson Education, Inc.

Mechanisms of Antimicrobial Action • Inhibition of Cell Wall Synthesis • Inhibition of synthesis of bacterial walls • Prevent bacteria from increasing amount of peptidoglycan • Have no effect on existing peptidoglycan layer • Effective only for growing cells © 2018 Pearson Education, Inc.

Mechanisms of Antimicrobial Action • Inhibition of Cell Wall Synthesis • Inhibition of synthesis of bacterial walls • Most common agents prevent cross-linkage of NAM subunits • Beta-lactams are most prominent in this group • Functional groups are beta-lactam rings • Beta-lactams bind to enzymes that cross-link NAM subunits with pentapeptides (prevent cross-hatching; think of nylons with “runners”) • Bacteria have weakened cell walls that cannot be built or repaired and eventually lyse © 2018 Pearson Education, Inc.

Figure 10. 3 a-b Bacterial cell wall synthesis and the inhibitory effects of betalactams on it. Growth of cell wall under normal circumstances: pentapeptide crosslinks the NAM’s and crosshatches each peptidoglycan layer © 2018 Pearson Education, Inc.

Figure 10. 3 c-e Bacterial cell wall synthesis and the inhibitory effects of betalactams on it. © 2018 Pearson Education, Inc.

Mechanisms of Antimicrobial Action • Inhibition of Cell Wall Synthesis • Inhibition of synthesis of bacterial walls • Semisynthetic derivatives of beta-lactams • More stable in acidic environments (e. g. , stomach) • More readily absorbed into stomach and intestines • Less susceptible to deactivation by liver enzymes • More active against more types of bacteria (especially gram-negative bacteria) © 2018 Pearson Education, Inc.

Mechanisms of Antimicrobial Action • Inhibition of Cell Wall Synthesis • Inhibition of synthesis of bacterial walls • Vancomycin and cycloserine • Interfere with formation of particular bridges that will ultimately link NAM subunits in many Gram-positive bacteria • This step precedes the crosslinking the formed bridges discussed before • Bacitracin • Blocks transport of NAG and NAM from cytoplasm • Isoniazid and ethambutol • Disrupt mycolic acid formation in mycobacterial species • Causes mycobacterial cell walls to be far more sensitive to other antibiotics and cellular immune system © 2018 Pearson Education, Inc.

Mechanisms of Antimicrobial Action • Inhibition of Cell Wall Synthesis • Inhibition of synthesis of fungal walls • Fungal cells composed of various polysaccharides not found in mammalian cells • Echinocandins inhibit the enzyme that synthesizes glucan © 2018 Pearson Education, Inc.

Mechanisms of Antimicrobial Action • Inhibition of Protein Synthesis • Interference with prokaryotic ribosomes • • Prokaryotic ribosomes are 70 S (30 S and 50 S) Eukaryotic ribosomes are 80 S (40 S and 60 S) Drugs can selectively target translation Mitochondria of animals and humans contain prokaryotic-like 70 S ribosomes • Can be harmful – source of human toxicity when allergic reactions are not seen © 2018 Pearson Education, Inc.

Figure 10. 4 Some mechanisms by which antimicrobials target prokaryotic ribosomes to inhibit protein synthesis. © 2018 Pearson Education, Inc.

Mechanisms of Antimicrobial Action • Inhibition of Protein Synthesis • Interference with charging of transfer RNA molecules • Aminoacyl-t. RNA synthetases load amino acids onto t. RNA molecules • Mupirocin selectively binds to isoleucyl-t. RNA synthetase • Prevents loading of isoleucine only in Gram-positive bacteria © 2018 Pearson Education, Inc.

Mechanisms of Antimicrobial Action • Disruption of Cytoplasmic Membranes • Some drugs form channel through cytoplasmic membrane and damage its integrity • Nystatin and amphotericin B attach to ergosterol in fungal membranes • Humans somewhat susceptible because cholesterol similar to ergosterol and nystatin and amphotericin will bind cholesterol weakly • Bacteria lack sterols; these drugs cannot affect bacteria and so they are not susceptible • Polymyxin disrupts cytoplasmic membranes of Gramnegative bacteria (outer membrane crucial to function) • Toxic to human kidneys • Some parasitic drugs act against cytoplasmic membranes; often human toxicity © 2018 Pearson Education, Inc.

Figure 10. 5 Disruption of the cytoplasmic membrane by the antifungal amphotericin B. © 2018 Pearson Education, Inc.

Mechanisms of Antimicrobial Action • Inhibition of Metabolic Pathways • Antimetabolic agents can be effective when pathogen and host metabolic processes differ • Heavy metals inactivate enzymes • Agents that disrupt tubulin polymerization and glucose uptake by many protozoa and parasitic worms • Drugs that block activation of viruses • Metabolic antagonists © 2018 Pearson Education, Inc.

Figure 10. 6 The antimetabolic action of sulfonamides in inhibiting nucleic acid synthesis. © 2018 Pearson Education, Inc.

Mechanisms of Antimicrobial Action • Inhibition of Metabolic Pathways • Trimethoprim also interferes with nucleotide synthesis. • Antiviral agents can target unique aspects of viral metabolism. • Amantadine, rimantadine, and weak organic bases prevent viral uncoating. • Protease inhibitors interfere with an enzyme that HIV needs in its replication cycle. © 2018 Pearson Education, Inc.

Mechanisms of Antimicrobial Action • Inhibition of Nucleic Acid Synthesis • • Several drugs block DNA replication or RNA transcription Drugs often affect both eukaryotic and prokaryotic cells Not normally used to treat infections Used in research and perhaps to slow cancer cell replication © 2018 Pearson Education, Inc.

Mechanisms of Antimicrobial Action • Inhibition of Nucleic Acid Synthesis • Quinolones and fluoroquinolones • Act against prokaryotic DNA gyrase • Nucleotide or nucleoside analogs • Interfere with function of nucleic acids • Distort shapes of nucleic acid molecules and prevent further replication, transcription, or translation • Most often used against viruses • Effective against rapidly dividing cancer cells and rapidly dividing prokaryotic cells © 2018 Pearson Education, Inc.

Figure 10. 7 Nucleosides and some of their antimicrobial analogs. The movie “Dallas Buyers Club” featured AZT (OD and toxic) and dd. C (neurotoxic) © 2018 Pearson Education, Inc.

Mechanisms of Antimicrobial Action • Inhibition of Nucleic Acid Synthesis • Inhibitors of RNA polymerase • Reverse transcriptase inhibitors • Act against an enzyme HIV uses in its replication cycle • Do not harm people because humans lack reverse transcriptase © 2018 Pearson Education, Inc.

Mechanisms of Antimicrobial Action • Prevention of Virus Attachment, Entry, or Uncoating • Attachment antagonists block viral attachment or receptor proteins • New area of antimicrobial drug development • Pleconaril blocks viral attachment • Arildone prevents viral uncoating © 2018 Pearson Education, Inc.

Clinical Considerations in Prescribing Antimicrobial Drugs • Ideal Antimicrobial Agent • • • Readily available Inexpensive Chemically stable Easily administered Nontoxic and nonallergenic Selectively toxic against wide range of pathogens © 2018 Pearson Education, Inc.

Clinical Considerations in Prescribing Antimicrobial Drugs • Spectrum of Action • Number of different pathogens a drug acts against • Narrow-spectrum effective against few organisms • Broad-spectrum effective against many organisms • May allow for secondary or superinfections to develop (especially of fungal origin) • Killing of normal flora reduces microbial antagonism © 2018 Pearson Education, Inc.

Figure 10. 8 Spectrum of action for selected antimicrobial agents. © 2018 Pearson Education, Inc.

Clinical Considerations in Prescribing Antimicrobial Drugs • Effectiveness • Ascertained by • Diffusion susceptibility test • Kirby-Bauer • Minimum inhibitory concentration test • Smallest amount that will inhibit growth • Minimum bactericidal concentration test • Smallest amount to kill microbe instead of simply stop growth © 2018 Pearson Education, Inc.
Figure 10. 9 Zones of inhibition in a diffusion susceptibility (Kirby-Bauer) test. © 2018 Pearson Education, Inc.

Figure 10. 10 Minimum inhibitory concentration (MIC) test in wells. © 2018 Pearson Education, Inc.
Figure 10. 11 An E-test, which combines aspects of Kirby-Bauer and MIC tests. © 2018 Pearson Education, Inc.

Clinical Considerations in Prescribing Antimicrobial Drugs • Routes of Administration • Topical application of drug for external infections • Oral route requires no needles and is self-administered • Intramuscular administration delivers drug via needle into muscle; levels never close to that of IV • Intravenous administration (needle a/o catheter) delivers drug directly to bloodstream • Kidneys and liver remove drug from circulation • Must know how antimicrobial agent will be distributed to infected tissues © 2018 Pearson Education, Inc.

Figure 10. 13 The effect of route of administration on blood levels of a chemotherapeutic agent. © 2018 Pearson Education, Inc.

Clinical Considerations in Prescribing Antimicrobial Drugs • Safety and Side Effects • Toxicity • Cause of many adverse reactions poorly understood • Drugs may be toxic to kidneys, liver, or nerves • Consideration needed when prescribing drugs to pregnant women • Therapeutic index is the ratio of the dose of a drug that can be tolerated to the drug's effective dose • If much greater than 1, the drug can be used at high levels before toxic effects are seen • If close to 1, then drug will cause side effects very easily when therapeutic doses seen • If less than 1, then what? © 2018 Pearson Education, Inc.

Figure 10. 14 Some side effects resulting from toxicity of antimicrobial agents. © 2018 Pearson Education, Inc.

Clinical Considerations in Prescribing Antimicrobial Drugs • Safety and Side Effects • Allergies • Allergic reactions are rare but may be life threatening • Anaphylactic shock • Immune system sets up systemic protection if small fast “foreign molecule” is found throughout too quickly • Disruption of normal microbiota • May result in secondary infections (dominant pathogenic organism changes) • Overgrowth of normal (often, minority) flora causing superinfections • Of greatest concern for hospitalized patients © 2018 Pearson Education, Inc.

Resistance to Antimicrobial Drugs • The Development of Resistance in Populations • Some pathogens are naturally resistant • Resistance by bacteria acquired in two ways: • New mutations of chromosomal genes • Uncommon • Acquisition of R plasmids via transformation, transduction, and conjugation • Most cases of multi-drug resistance involved these mechanisms © 2018 Pearson Education, Inc.

Figure 10. 15 The development of a resistant strain of bacteria. © 2018 Pearson Education, Inc.

Resistance to Antimicrobial Drugs • Mechanisms of Resistance • At least seven mechanisms of microbial resistance • • Produce enzyme that destroys or deactivates drug Slows or prevents entry of drug into the cell Alter target of drug so it binds less effectively Alter their own metabolic chemistry to circumvent drug effect • Pump antimicrobial drug out of the cell before it can act (especially common with porins in gram-negative bacteria) • Bacteria in biofilms can resist antimicrobials • Mycobacterium tuberculosis produces Mfp. A protein • Binds DNA gyrase, preventing the binding of fluoroquinolone drugs © 2018 Pearson Education, Inc.

Figure 10. 16 How beta-lactamase (penicillinase) renders penicillin inactive. © 2018 Pearson Education, Inc.

Resistance to Antimicrobial Drugs • Multiple Resistance and Cross Resistance • Pathogen can acquire resistance to more than one drug • Common when R plasmids exchanged • Develop in hospitals and nursing homes • Constant use of drugs eliminates sensitive cells • Favors expansion of resistant cells (superinfection? ) • Multiple-drug-resistant pathogens are resistant to at least three antimicrobial agents • S. aureus, K. pneumonia, M. tuberculosis • Cross resistance can occur when drugs are similar in structure © 2018 Pearson Education, Inc.

Resistance to Antimicrobial Drugs • Retarding Resistance • Maintain high concentration of drug in patient for sufficient time • Inhibit the pathogen so immune system can eliminate • Inhibit the resistance factor • Allows antibiotics to become useful again • Use antimicrobial agents in combination • Synergism occurs when one drug enhances the effect of a second drug • Antagonism occurs when drugs interfere with each other © 2018 Pearson Education, Inc.

Figure 10. 17 An example of synergism between two antimicrobial agents. © 2018 Pearson Education, Inc.

Resistance to Antimicrobial Drugs • Retarding Resistance • Use antimicrobials only when necessary • Develop new variations of existing drugs • Second-generation drugs • Third-generation drugs • Fourth-generation drugs • Search for new antibiotics, semisynthetics, and synthetics • Bacteriocins • Design drugs complementary to the shape of microbial proteins to inhibit them – should be harder to develop resistance, but few compounds have been discovered through this strategy © 2018 Pearson Education, Inc.

The Ongoing Battle of the Mouse and the Mousetrap Penicillin G/V natural compounds had inconveniences; narrow spectrum Aminopenicillins: Oxacillin, Ampicillin Amoxicillin Bla gene becomes common; insufficiently wide spectrum (1) Methicillin Penicillins + clavulanates (4) Carbapenems: Imipenem (+ cilastatin) = Primaxin (2) Carboxycillins: Carbenicillin, ticarcillin (3) Ureidopenicillins: Mezlocillin, Azlocillin (5) Monobactams Aztreonam (6) Cephalosporins: Narrow spectrum but nontoxic (6. 1) cephalothin (6. 2) cefamandol, cefalcor (6. 3) cefixime (6. 4) cefepime (6. 5) ceftobiprole newly isolated drug Bla gene mutants circumvent; appearance of MRSA Inhibit earlier steps Of cell wall synthesis: Bacitracin (topical), Vancomycin, cycloserine © 2018 Pearson Education, Inc. Vancomycin-resistant Enterococci (VRE) VRE genes appears in MRSA = VRSA Second-gen. vancomycins: telavancin oritavancin
![[INSERT TABLE 10. 2] © 2018 Pearson Education, Inc. [INSERT TABLE 10. 2] © 2018 Pearson Education, Inc.](http://slidetodoc.com/presentation_image_h/2ba698cef3afa99eca2e6a9f732742ff/image-50.jpg)
[INSERT TABLE 10. 2] © 2018 Pearson Education, Inc.
![[INSERT TABLE 10. 2] © 2018 Pearson Education, Inc. [INSERT TABLE 10. 2] © 2018 Pearson Education, Inc.](http://slidetodoc.com/presentation_image_h/2ba698cef3afa99eca2e6a9f732742ff/image-51.jpg)
[INSERT TABLE 10. 2] © 2018 Pearson Education, Inc.
![[INSERT TABLE 10. 2] © 2018 Pearson Education, Inc. [INSERT TABLE 10. 2] © 2018 Pearson Education, Inc.](http://slidetodoc.com/presentation_image_h/2ba698cef3afa99eca2e6a9f732742ff/image-52.jpg)
[INSERT TABLE 10. 2] © 2018 Pearson Education, Inc.
![[INSERT TABLE 10. 2] © 2018 Pearson Education, Inc. [INSERT TABLE 10. 2] © 2018 Pearson Education, Inc.](http://slidetodoc.com/presentation_image_h/2ba698cef3afa99eca2e6a9f732742ff/image-53.jpg)
[INSERT TABLE 10. 2] © 2018 Pearson Education, Inc.
![[INSERT TABLE 10. 2] © 2018 Pearson Education, Inc. [INSERT TABLE 10. 2] © 2018 Pearson Education, Inc.](http://slidetodoc.com/presentation_image_h/2ba698cef3afa99eca2e6a9f732742ff/image-54.jpg)
[INSERT TABLE 10. 2] © 2018 Pearson Education, Inc.
![[INSERT TABLE 10. 3] © 2018 Pearson Education, Inc. [INSERT TABLE 10. 3] © 2018 Pearson Education, Inc.](http://slidetodoc.com/presentation_image_h/2ba698cef3afa99eca2e6a9f732742ff/image-55.jpg)
[INSERT TABLE 10. 3] © 2018 Pearson Education, Inc.
![[INSERT TABLE 10. 3] © 2018 Pearson Education, Inc. [INSERT TABLE 10. 3] © 2018 Pearson Education, Inc.](http://slidetodoc.com/presentation_image_h/2ba698cef3afa99eca2e6a9f732742ff/image-56.jpg)
[INSERT TABLE 10. 3] © 2018 Pearson Education, Inc.
![[INSERT TABLE 10. 3] © 2018 Pearson Education, Inc. [INSERT TABLE 10. 3] © 2018 Pearson Education, Inc.](http://slidetodoc.com/presentation_image_h/2ba698cef3afa99eca2e6a9f732742ff/image-57.jpg)
[INSERT TABLE 10. 3] © 2018 Pearson Education, Inc.
![[INSERT TABLE 10. 4] © 2018 Pearson Education, Inc. [INSERT TABLE 10. 4] © 2018 Pearson Education, Inc.](http://slidetodoc.com/presentation_image_h/2ba698cef3afa99eca2e6a9f732742ff/image-58.jpg)
[INSERT TABLE 10. 4] © 2018 Pearson Education, Inc.
![[INSERT TABLE 10. 5] © 2018 Pearson Education, Inc. [INSERT TABLE 10. 5] © 2018 Pearson Education, Inc.](http://slidetodoc.com/presentation_image_h/2ba698cef3afa99eca2e6a9f732742ff/image-59.jpg)
[INSERT TABLE 10. 5] © 2018 Pearson Education, Inc.
![[INSERT TABLE 10. 5] © 2018 Pearson Education, Inc. [INSERT TABLE 10. 5] © 2018 Pearson Education, Inc.](http://slidetodoc.com/presentation_image_h/2ba698cef3afa99eca2e6a9f732742ff/image-60.jpg)
[INSERT TABLE 10. 5] © 2018 Pearson Education, Inc.
![[INSERT TABLE 10. 6] © 2018 Pearson Education, Inc. [INSERT TABLE 10. 6] © 2018 Pearson Education, Inc.](http://slidetodoc.com/presentation_image_h/2ba698cef3afa99eca2e6a9f732742ff/image-61.jpg)
[INSERT TABLE 10. 6] © 2018 Pearson Education, Inc.
![[INSERT TABLE 10. 6] © 2018 Pearson Education, Inc. [INSERT TABLE 10. 6] © 2018 Pearson Education, Inc.](http://slidetodoc.com/presentation_image_h/2ba698cef3afa99eca2e6a9f732742ff/image-62.jpg)
[INSERT TABLE 10. 6] © 2018 Pearson Education, Inc.
![[INSERT TABLE 10. 6] © 2018 Pearson Education, Inc. [INSERT TABLE 10. 6] © 2018 Pearson Education, Inc.](http://slidetodoc.com/presentation_image_h/2ba698cef3afa99eca2e6a9f732742ff/image-63.jpg)
[INSERT TABLE 10. 6] © 2018 Pearson Education, Inc.
- Slides: 63